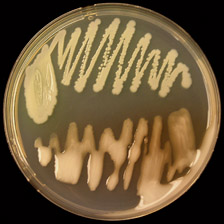
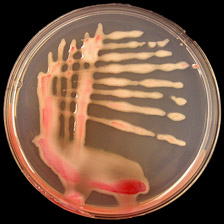

Peer-Reviewed by Plant Health Progress
© 2009 Plant Management Network.
Accepted for publication 17 January 2009. Published 13 March 2009.
Patrice G. Champoiseau, Research Associate, and Jeffrey B. Jones, Professor, Department of Plant Pathology, University of Florida, Gainesville, FL 32611; and Caitilyn Allen, Professor, Department of Plant Pathology, University of Wisconsin, Madison, WI 53706
Corresponding author: Caitilyn Allen. cza@plantpath.wisc.edu
Champoiseau, P. G., Jones, J. B., and Allen, C. 2009. Ralstonia solanacearum race 3 biovar 2 causes tropical losses and temperate anxieties. Online. Plant Health Progress doi:10.1094/PHP-2009-0313-01-RV.

Introduction
Bacterial wilts caused by Ralstonia solanacearum (Smith 1986) Yabuuchi et al. 1996 (formerly called Pseudomonas solanacearum) have long been a scourge of tropical agriculture because the pathogen is very widely distributed and has an unusually broad host range (7,13). Moreover, because R. solanacearum is a soilborne pathogen and host resistance is limited, bacterial wilt is very difficult to control (13,26).
Bacterial wilt disease generally occurs in lowlands in tropical or subtropical areas, but one subgroup of R. solanacearum called Race 3 biovar 2 (R3bv2) attacks plants at higher altitudes or in temperate zones. R3bv2 is an extremely destructive potato pathogen, causing brown rot of potato in the highland tropics of Africa, Asia, and Latin America. It has recently appeared in Europe where it disrupted seed potato production and caused serious quarantine-related losses (8,15). In the United States, R3bv2 was listed in 2002 as a Select Agent plant pathogen, and is now subject to the strictest biosecurity regulations (20).
R. solanacearum is considered a "species complex," due to significant variation within the group (11). It was historically subdivided into five races, based loosely on host range, and five biovars, based on ability to acidify a panel of 5 to 8 carbohydrate substrates, but this old classification system has proved to be unsatisfactory. There are no laboratory tests to define the "race" of an isolate because host ranges of strains are broad and often overlap. The biovars do not correspond to phylogenetically coherent groups, with the exception of biovar 2A, which corresponds to R3bv2. Moreover, a subgroup of biovar 2, known as biovar 2T, is present in strains from Asia and Africa as well as strains in the original "biovar 2" group from South America, which means that the traditional biovar test is not completely reliable for diagnostic purposes. Recently, a phylogenetically meaningful classification scheme was developed based on DNA sequence analysis (11,24). This scheme divides the species complex into four phylotypes that broadly reflect the ancestral relationships and geographical origins of the strains. Phylotype I strains originated in Asia, phylotype II strains originated in the Americas, phylotype III strains in Africa, and phylotype IV strains in Indonesia. Phylotypes are further subdivided into sequevars based on the sequence of the endoglucanase (egl) gene (11,24). Multi-locus sequence typing and other analyses have confirmed that this system of classification reflects the phylogeny of the group. R. solanacearum R3bv2 strains belong to phylotype II and sequevars 1 and 2 (11). R3bv2 probably originated in the Andes, and sequevar 1 was apparently disseminated worldwide on potato tubers; this group now occurs in tropical highlands and in subtropical and warm-temperate areas throughout the world, except in North America. It is responsible for an estimated $1 billion US in losses each year (8).
Initially described as pathogenic on potato and tomato, R3bv2 can also wilt eggplant, pepper, and geranium (where it causes Southern wilt disease). Many solanaceous and non-solanaceous plants are alternate hosts (16,23,30,34). Bittersweet nightshade (Solanum dulcamara) is an epidemiologically important weed host of R. solanacearum in Europe. R3bv2 has been accidentally introduced to the United States several times on infected geranium cuttings imported from off-shore production sites, but the pathogen was apparently eradicated (3,19,28,35). Apart from its status as a Select Agent, R3bv2 is considered a serious quarantine pest by the Animal and Plant Health Inspection Service (APHIS) of the United States Department of Agriculture (USDA), by the North American Plant Protection Organization (NAPPO), and by the European Plant Protection Organization (EPPO).
Symptoms on Potato and Tomato
R3bv2 induces similar symptoms on potato and tomato, and these cannot be distinguished from wilt symptoms caused by other R. solanacearum strains. The first visible symptoms are wilting of the youngest leaves during the hottest part of the day, often on just one side of a leaflet or on a single branch (Fig. 1). At this stage, plants may appear to recover at night when temperatures are cooler. Under favorable conditions, the entire plant may wilt quickly, leading to general wilting and yellowing of foliage and eventually plant death. Wilted leaves of infected potato plants can become desiccated, although dried leaves remain green. Another common symptom associated with bacterial wilt in the field is plant stunting (Fig. 2). These symptoms may appear at any stage of plant growth; sometimes, infected tomato plants will not show symptoms until just before fruit ripening, when they undergo rapid collapse. A longitudinal slice of infected stems or stolons will reveal vascular browning, visible as long, narrow, dark brown streaks (Fig. 3). In succulent young plants of highly susceptible varieties, the stem can collapse (Fig. 4), and grey-white bacterial ooze may be visible on stem surfaces (1).
| |
 |
|
 |
|
| |
Fig. 1. Symptoms of potato brown rot (A) and tomato bacterial wilt (B) caused by R. solanacearum showing wilt of youngest leaves (photo A courtesy of D. P. Weingartner, IFAS, University of Florida, Hastings; photo B courtesy of Clemson University, USDA Cooperative Extension Slide Series, Bugwood.org). |
|
Fig. 2. Symptoms of potato brown rot (A) and tomato bacterial wilt (B) caused by R. solanacearum showing wilting and stunting of plants (photo A courtesy of H. David Thurston, Cornell University; photo B courtesy of C. Allen, University of Wisconsin).
| |
 |
|
 |
|
| |
Fig. 3. Brown discoloration of stem tissues caused by R. solanacearum (photo courtesy of Clemson University, USDA Cooperative Extension Slide Series, Bugwood.org). |
|
Fig. 4. Symptom of tomato bacterial wilt caused by R. solanacearum showing collapse of young stem and stem bacterial ooze after artificial inoculation of the plant (photo courtesy of P. Champoiseau, University of Florida). |
|
In potato, brown rot symptoms may be visible in tubers as disease develops (1). Cross-section of infected tubers often reveals a grey-brown discoloration of vascular tissues, commonly called a vascular ring (Fig. 5). As infection progresses, the discoloration may extend into the pith or cortex of the tuber. A milky-white sticky exudate or ooze, consisting of bacterial cells and their extracellular polysaccharide, is usually noticeable in freshly cut-sections of infected tubers (Fig. 5). This ooze may form visible threads when the two sides of a cut tuber are pressed together and then pulled apart.
| |

Fig. 5. Grey-brown discoloration of vascular tissues (vascular ring) and bacterial ooze in potato tuber infected by R. solanacearum (photo courtesy of K. Tsuchiya, Japan). |
|
Symptoms on Geranium
In geranium, symptoms of Southern wilt can be subtle and easily overlooked. Symptoms usually begin with chlorosis and wilting of the lower leaves, then progress to an upward curling of leaf margins that is very characteristic (Fig. 6). At this stage of disease, plants may appear to recover at night when temperatures are cooler. Under favorable conditions, the disease develops rapidly on geraniums and wilting may move upwards from older to younger leaves. Wilted leaves often develop wedge-shaped areas of chlorosis that become necrotic. The leaf margins may also become chlorotic, then necrotic, and the whole plant may desiccate and die (Fig. 7). In late stages of disease, stems may collapse (Fig. 8). Vascular discoloration is visible in stems (especially at the root crown) and roots; these can blacken and eventually become necrotic (Fig. 9).
 |
|
 |
|
Fig. 6. Initial symptoms of Southern wilt of geranium caused by R. solanacearum showing wilting and curling of leaves (photo courtesy of D. Norman, Mid-Florida Research and Education Center, IFAS, University of Florida). |
|
Fig. 7. Symptoms of Southern wilt of geranium caused by R. solanacearum R3bv2 showing drying and brown necrosis on leaves (photo courtesy of the Wisconsin Department of Agriculture, Trade and Consumer Protection). |
 |
|
 |
|
Fig. 8. Late symptoms of Southern wilt of geranium caused by R. solanacearum R3bv2 showing blackening and collapse of stem (photo courtesy of D. Norman, Mid-Florida Research and Education Center, IFAS, University of Florida). |
|
Fig. 9. Late symptoms of Southern wilt of geranium showing root blackening (photo courtesy of Margery Daughtrey, Cornell University, www.pdis.org). |
Symptom expression in geranium is favored by high temperatures (29 to 35°C). Although R3bv2 readily infects geranium plants, it is not an especially aggressive pathogen on this host. Therefore, it often causes latent (symptomless) infections, and latently infected geraniums may appear healthy for several months (29). Latently infected plants can contain large populations of R3bv2 (up to 108 cells/g. of stem tissue) and often shed large numbers of bacteria from their roots into run-off water or soil (29). Alternate hosts of R. solanacearum such as S. dulcamara often appear healthy, even when infected. However, when wilt symptoms appear, they are similar to those described for tomato.
Diagnostic Signs of Bacterial Wilt and Brown Rot
Bacterial streaming is a common diagnostic sign of bacterial wilt diseases (1). When cut stem sections from infected plants are placed in water, threads of a viscous white slime can be observed streaming from the cut end of the stem within 15 min. These threads are bacterial ooze exuding from the infected xylem vascular bundles (Fig. 10). This streaming test is a valuable diagnostic tool for quick detection of bacterial wilt or brown rot in the field. Bacterial ooze may also emerge from the vascular ring of cut potato tubers, as described above. Ooze from intact tubers at eyes or where the stolon attaches may cause dirt to adhere to tubers. This symptom may not be visible early in disease development.
| |
 |
|
Fig. 10. Bacterial streaming in clear water from stem cross section of plant infected by R. solanacearum (photo courtesy of D. B. Langston, University of Georgia, Bugwood.org). |
|
Culture, Detection and Identification
Ralstonia solanacearum is a Gram-negative, rod-shaped, strictly aerobic bacterium that is 0.5-0.7 × 1.5-2.0 µm in size. For most strains, the optimal growth temperature is between 28 and 32°C (13,27). On solid agar media, individual bacterial colonies are usually visible after 36 to 48 hours growth at 28°C, and colonies of the normal or virulent type are white or cream-colored, irregularly shaped, highly fluidal, and opaque. Occasionally, colonies of the mutant or non-virulent type appear; these are uniformly round, smaller, and butyrous, or dry (Fig. 11a). A tetrazolium chloride (TZC) medium (18) can differentiate the two colony types. On this medium, virulent colonies appear white with pink centers and non-virulent colonies are a uniform dark red (Fig. 11b).
A |
|
B |
Fig. 11. (A) Virulent (bottom) and non-virulent (top) colonies of R. solanacearum on CPG agar growth medium; (B) Virulent colonies of R. solanacearum on TZC agar medium (photos courtesy of P. Champoiseau, University of Florida).
R. solanacearum can be stored for many years at room temperature in sterilized tap, distilled or deionized water. It will also survive long-term at -80°C in liquid culture broth amended to 40% glycerol. This pathogen easily loses virulence if repeatedly transferred on agar plates and loses viability if plates are stored at 4°C. This bacterium is known to enter a viable but not culturable (VBNC) state under some circumstances, such as exposure to low temperatures; this may complicate culture-based diagnostic methods (31).
Disease Cycle and Epidemiology
R. solanacearum primarily infects host plants through their roots, entering through wounds formed by lateral root emergence or by root damage caused by soilborne organisms (e.g., the root-knot nematode). The bacterium can also enter plants by way of stem injuries from insects, handling, or tools. Once bacteria infect the roots or stems, they colonize the plant through the xylem in the vascular bundles. R3bv2 is most severe on plants between 24 and 35°C and decreases in aggressiveness when temperatures exceed 35°C or fall below 16°C. Active disease at temperatures below 16°C is rare (6,13).
Vegetative propagation can play a major role in dissemination of R3bv2, particularly via latently infected potato seed tubers and infected geranium cuttings. Plant-to-plant infection can occur when bacteria shed from infected roots move to roots of nearby healthy plants. The pathogen can be spread from infested to healthy fields by soil transfer on machinery and surface runoff water after irrigation or rainfall. It also can be disseminated from infested ponds or rivers to healthy fields by flooding or irrigation.

Fig. 12. Key features for identification of Solanum dulcamara (bittersweet nightshade, also known as climbing or woody nightshade) (photo courtesy of J. Elphinstone, Central Science Laboratory, York, UK, Crown copyright). |
|
R. solanacearum is primarily a soilborne and waterborne pathogen. No aerial spread of the pathogen has been reported. The bacterium can survive for days to years in infested water, wet soils or deep soil layers (> 75 cm), forming a reservoir of inoculum from which it can disperse. Diverse biological (such as antagonist microorganisms) and environmental (mainly temperature and soil moisture) factors can affect survival of R. solanacearum in soil and aquatic habitats. Bacterial populations decrease rapidly at low temperatures (< 4°C), but R3bv2 can still survive, in a physiologically latent, viable, but non-culturable (VBNC) state. In natural habitats, R3bv2 can survive moderate winters in host weeds or in the rhizosphere of non-host plants, which act as inoculum reservoirs. Recent outbreaks of brown rot of potato in the United Kingdom were traced to R. solanacearum-infected semi-aquatic S. dulcamara plants (Fig. 12), which released the pathogen from roots into river waters that were subsequently used for potato irrigation.
Because R3bv2 is shed abundantly from the roots of latently-infected geraniums, ebb-and-flow sub-irrigation systems in greenhouse production are conductive to bacterial dissemination and pose a major risk for plant-to-plant spread of R3bv2 (29).
Detection and Identification
R. solanacearum R3bv2 can be identified following recovery from either symptomatic or asymptomatic plants and from water or soil samples by means of several microbiological and molecular methods (25,27,33). A combination of at least two different complementary tests is needed to unambiguously identify the species and biovar. Screening tests can facilitate early detection of R. solanacearum in plants or contaminated soil and water samples, but they cannot be used to identify the race or biovar. These screening tests include bacterial streaming, plating on a semi-selective medium such as modified SMSA (9), immunodiagnostic assays using species-specific antibodies, polymerase chain reaction (PCR) with species-specific primers, and pathogenicity tests using susceptible hosts such as tomato seedlings (9,27,33). Commercially-available immunostrips (Agdia or CSL Pocket Diagnostics) can be used for rapid detection of R. solanacearum in the field or lab. The biovar test, a bacteriological assay based on the differential ability of R. solanacearum strains to produce acid from a panel of disaccharides and sugar alcohols, requires specialized media and takes several weeks (14,27).
Strains of R. solanacearum can be sub-classified into phylotypes and then into sequevars using PCR and gene sequence analysis (11,24). Race determination is not possible, because R. solanacearum strains do not have race-cultivar specificity on plant hosts and, with the exception of R3bv2, the old "races" do not have phylogenetic unity. Unequivocal identification of R3bv2 must rely on at least two distinct methods, including the biovar test and one of the DNA-based tests that use PCR to amplify an R3bv2-specific DNA fragment. Because of current United States regulations, the only laboratory legally permitted to conclusively identify R3bv2 is the USDA-APHIS-PPQ National Plant Germplasm and Biotechnology Laboratory in Beltsville, MD. A diagnostician who identifies R. solanacearum in samples from potato or geranium should consider the possibility that the strain may be R3bv2 and immediately contact the APHIS-PPQ lab in Beltsville.
Disease Management
Bacterial wilt is difficult to control. Moderate horizontal resistance (tolerance) to R. solanacearum strains has been reported in potato and tomato, but few assays for wilt resistance in tomato have included R3bv2 strains (5). Some reports suggest that bacterial wilt-resistant tomato cultivars and breeding lines may have poor resistance to R3bv2 (P. Prior, personal communication). However, host plant resistance has not been very effective for control of bacterial wilt on potato or tomato, since resistance often varies among locations because of strain differences (12,32). In potato, resistance often fails at warmer temperatures. Grafting susceptible tomato cultivars onto resistant tomato or other solanaceous rootstocks is effective on the commercial scale in Japan, Bangladesh, and the Philippines, but grafting has not been tested for use against R3bv2. The use of soil fumigants or antibiotics is environmentally destructive, expensive, and largely ineffective against bacterial wilt (26). Thus, options for control of bacterial wilt in the field consist primarily of phytosanitation and cultural practices.
In regions where the pathogen is established, cultural practices can be effective under some conditions. These practices include crop rotation with non-host plants such as grasses, intercropping, control of weed and root-knot nematode populations, planting at non-infested production sites, removal of weeds or crop residue where inoculum persists, selection of appropriate planting time to avoid heat, deep plowing of crop residues, satisfactory soil drainage, and early- and late-season irrigation management (13,26). Chemical and soil treatments, such as modification of soil pH, heat treatment by solarization, and the application of stable bleaching powder, as well as plant resistance inducers (e.g., acibenzolar-S-methyl), plant essential oils (e.g., thymol), or phosphorous acid have been shown to reduce bacterial populations and disease severity on a small scale (2,17,22,26). Drawbacks of these methods may include environmental damage, cost, and high labor inputs. The efficacy of these treatments needs to be validated on a commercial scale, and most have not been tested against R3bv2 strains of R. solanacearum. Similarly, biological control based on suppressive soils or known R. solanacearum antagonists has shown promising results in small scale experiments, but still needs to be validated on a larger scale and against R3bv2 (26).
In areas where the pathogen is present but not yet established everywhere, it is critically important to observe good cultural sanitation practices to keep non-infested areas clean. Sanitation efforts include planting only certified disease-free seed potatoes or cuttings, disinfesting all equipment before moving between fields, controlling floodwater flow, and never using surface water for irrigation. Even where R. solanacearum is present in soils, as in many parts of the African highlands, use of disease-free seed potatoes can significantly reduce disease incidence and allow growers to harvest a profitable crop.
In areas where the bacterium is not known to be established, the first strategy is to prevent introduction and, if inadvertently introduced, subsequent movement of the pathogen. Government regulations in the United States include zero tolerance for R. solanacearum R3bv2, since it is classified as a Select Agent. This zero tolerance includes reinforcement of quarantine regulations, sanitation protocols, and inspections designed to prevent introduction of infected geranium cuttings produced off-shore.
In the United States "Guidelines for management of R. solanacearum race 3 biovar 2" (3) and a "Recovery plan for Ralstonia solanacearum race 3 biovar 2" (21) present current information for detection, control, containment, and eradication of this pathogen in compliance with regulations. APHIS-PPQ also developed "Minimum sanitation protocols for offshore geranium cutting production" (4) for use by off-shore geranium suppliers. It mandates implementation of sanitation procedures to prevent accidental introduction of R3bv2 and to ensure that, if it is introduced, the pathogen does not spread within greenhouses, or on equipment or vehicles.
In addition to establishing exclusionary strategies, growers should monitor potentially infested sites for early detection and subsequent eradication of R3bv2. Key sites for monitoring include soils in which R3bv2-infected plants have been identified, rivers and other surface water used for irrigation, particularly when infected host weeds may be present, and industrial and domestic waste products (including solids, liquids, and washing water). In Europe, discharge of liquid industrial and domestic effluents directly into waterways poses a high risk of spreading potato brown rot because it often leads to infection of S. dulcamara and subsequent survival and secondary spread of R3bv2.
In conclusion, R3bv2 is an important crop pathogen in both developing and industrialized countries. In North America and Europe it is a highly-regulated quarantine pest with the potential to disrupt trade. In the tropical highlands of Asia, Africa, and South/Central America it is a direct cause of hunger and economic hardship. Despite its importance, there are lamentably few options for control of R3bv2 and additional research is urgently needed to improve management of disease caused by this organism.
Acknowledgments
We thank Carrie L. Harmon and Timur M. Momol of the University of Florida for helpful critical review of this article. The authors gratefully acknowledge research materials from Agdia Inc. (Elkhart, IN) and support from USDA-CSREES Plant Biosecurity Award 2007-55605-17843.
Literature Cited
1. Allen, C., Kelman, A., and French, E. R. 2001. Brown rot of potatoes. Pages 11-13 in: Compendium of Potato Diseases, 2nd Edn. W. R. Stevenson, R. Loria, G. D. Franc, and D. P. Weingartner, eds. American Phytopathological Society, St. Paul, MN.
2. Anith, K. N., Momol, M. T., Kloepper, J. W., Marois, J. J., Olson S. M., and Jones, J. B. 2004. Efficacy of plant growth-promoting rhizobacteria, acibenzolar-S-methyl, and soil amendment for integrated management of bacterial wilt on tomato. Plant Dis. 88:669-673.
3. APHIS-PPQ. 2004. USDA-APHIS Pest Alert: Ralstonia solanacearum Race 3 biovar 2. Southern Wilt of Geranium. Issued Jan. 14, 2004. USDA-APHIS-PPQ Pest Detection and Management Programs, Riverdale, MD.
4. APHIS-PPQ. 2005. Minimum sanitation protocols for offshore geranium cutting production 2005. Issued Dec. 1, 2005. USDA-APHIS-PPQ Pest Detection and Management Programs, Riverdale, MD.
5. Boshou, L. 2005. A broad review and perspective on breeding for resistance to bacterial wilt. Pages 225-238 in: Bacterial Wilt Disease and the Ralstonia solanacearum Species Complex. C. Allen, P. Prior, and A. C. Hayward, eds. American Phytopathological Society, St. Paul, MN.
6. Ciampi, L., and Sequeira, L. 1980. Influence of temperature on virulence of Race 3 strains of Pseudomonas solanacearum. Am. Potato J. 57:307-317.
7. Denny, T. P. 2006. Plant pathogenic Ralstonia species. Pages 573-644 in: Plant-Associated Bacteria. S. S. Gnanamanickam, ed. Springer Publishing, Dordrecht, The Netherlands.
8. Elphinstone, J. G. 2005. The current bacterial wilt situation: A global overview. Pages 9-28 in: Bacterial Wilt: The Disease and the Ralstonia solanacearum Species Complex. C. Allen, P. Prior, and A. C. Hayward, eds. American Phytopathological Society, St. Paul, MN.
9. Elphinstone, J. G., Hennessey, J., Wilson, J. K., and Stead, D. E. 1996. Sensitivity of different methods for the detection of Ralstonia solanacearum in potato tuber extracts. EPPO Bull. 26:663-678.
10. Fegan, M., Holoway, G., Hayward, A. C., and Timmis, J. 1998. Development of a diagnostic test based on the polymerase chain reaction to identify strains of R. solanacearum exhibiting the biovar 2 genotype. Pages 34-43 in: Bacterial Wilt Disease: Molecular and Ecological Aspects. P. Prior, C. Allen, and J. Elphinstone, eds. Springer Verlag, Berlin, Germany.
11. Fegan, M., and Prior, P. 2005. How complex is the "Ralstonia solanacearum species complex"? Pages 449-461 in: Bacterial Wilt Disease and the Ralstonia solanacearum Species Complex. C. Allen, P. Prior, and A. C. Hayward, eds. American Phytopathological Society, St. Paul, MN.
12. Hanson, P. M., Wang, J. F., Licardo, O., Hanudin, Mah, S. Y., Hartman, G. L., Lin, Y. C., and Chen, J. T. 1996. Variable reactions of tomato lines to bacterial wilt evaluated at several locations in Southeast Asia. HortScience 31:143-146.
13. Hayward, A. C. 1991. Biology and epidemiology of bacterial wilt caused by Pseudomonas solanacearum. Annu. Rev. Phytopathol. 29:65-87.
14. Hayward, A. C. 1964. Characteristics of Pseudomonas solanacearum. J. Appl. Bacteriol. 27:265-277.
15. Janse, J. D. 1996. Potato brown rot in western Europe: History, present occurence and some remarks on possible origin, epidemiology and control strategies. EPPO Bull. 26:679-695.
16. Janse, J. D., van den Beld, H. E., Elphinstone, J., Simpkins, S., Tjou-Tam-Sin, N. A. A., and van Vaerenbergh, J. 2004. Introduction to Europe of Ralstonia solanacearum biovar 2, race 3 in Pelargonium zonale cuttings. J. Plant Pathol. 86:147-155.
17. Ji, P., Momol, M. T., Olson, S. M., and Pradhanang, P. M. 2005. Evaluation of thymol as biofumigant for control of bacterial wilt of tomato under field conditions. Plant Dis. 89:497-500.
18. Kelman, A. 1954. The relationship of pathogenicity of Pseudomonas solanacearum to colony appearance in a tetrazolium medium. Phytopathology 44:693-695.
19. Kim, S. H., Olson, T. N., Schaad, N. W., and Moorman, G. W. 2003. Ralstonia solanacearum Race 3, biovar 2, the causal agent of brown rot of potato, identified in geranium in Pennsylvania, Delaware, and Connecticut. Plant Dis. 87:450.
20. Lambert, C. D. 2002. Agricultural Bioterrorism Protection Act of 2002: Possession, Use, and Transfer of Biological; Agents and Toxins; Interim and Final Rule. (7 CFR Part 331). Federal Register 67:76908-76938.
21. Momol, T. M. 2006. Recovery Plan for Ralstonia solanacearum Race 3 biovar 2, causing brown rot of potato and southern wilt of geranium. Online. Natl. Plant Dis. Recovery Syst. (NPDRS), Dept. of Homeland Security, Washington, DC.
22. Norman, D. J., Chen, J., Yuen, J. M. F., Mangravita-Novo, A., Byrne, D., and Walsh, L. 2006. Control of bacterial wilt of geranium with phosphorous acid. Plant Dis. 90:798-802.
23. Pradhanang, P. M., Elphinstone, J. G., and Fox, R. T. V. 2000. Identification of crop and weed hosts of Ralstonia solanacearum biovar 2 in the hills of Nepal. Plant Pathol. 49:403-413.
24. Prior, P., and Fegan, M. 2005. Recent developments in the phylogeny and classification of Ralstonia solanacearum. Acta Hort. 695:127-136.
25. Priou, S., Gutarra, L., and Aley, P. 2006. Sensitive detection of Ralstonia solanacearum in soil: a comparison of different detection techniques. Plant Pathol. 49:414-422.
26. Saddler, G. S. 2005. Management of bacterial wilt disease. Pages 121-132 in: Bacterial Wilt Disease and the Ralstonia solanacearum Species Complex. C. Allen, P. Prior, and A. C. Hayward, eds. American Phytopathological Society, St. Paul, MN.
27. Schaad, N. W., Jones, J. B., and Chun, W. 2001. Laboratory Guide for the Identification of Plant Pathogenic Bacteria, 3rd Edn. American Phytopathological Society, St. Paul, MN.
28. Strider, D. L., Jones, R. K., and Haygood, R. A. 1981. Southern wilt of geranium caused by Pseudomonas solanacearum. Plant Dis. 65:52-53.
29. Swanson, J. K., Yao, J., Tans-Kersten, J. K. and Allen, C. 2005. Behavior of Ralstonia solanacearum race 3 biovar 2 during latent and active infection of geranium. Phytopathology 95:136-143.
30. Tusiime, G., Adipala, E., Opio, F., and Bhagsari, A. S. 1998. Weeds as latent hosts of Ralstonia solanacearum in highland Uganda: Implications to development of an integrated control package for bacterial wilt. Pages 413-419 in: Bacterial Wilt Disease: Molecular and Ecological Aspects. P. Prior, C. Allen, and J. Elphinstone, eds. Springer Verlag, Berlin, Germany.
31. van Elsas, J. D., Kastelein, P., de Vries, P. M., and van Overbeek, L. S. 2001. Effects of ecological factors on the survival and physiology of Ralstonia solanacearum bv. 2 in irrigation water. Can. J. Microbiol. 47:842-854.
32. Wang, J. F., Hanson, P., and Barnes, J. A. 1998. Worldwide evaluation of an international set of resistance sources to bacterial wilt in tomato. Pages 269-275 in: Bacterial Wilt Disease: Molecular and Ecological Aspects. P. Prior, C. Allen, and J. Elphinstone, eds. Springer Verlag, Berlin, Germany.
33. Weller, S. A., Elphinstone, J. G., Smith, N. C., Boonham, N., and Stead, D. 2000. Detection of Ralstonia solanacearum strains with a quantitative, multiplex, real-time fluorogenic PCR (TaqMan) assay. Appl. Environ. Microbiol. 66:2853-2858.
34. Wenneker, M., Verdel, M. S. W., Groeneveld, R. M. W., Kempenaar, C., van Beuningen, A. R., and Janse, J. D. 1999. Ralstonia (Pseudomonas) solanacearum race 3 (biovar 2) in surface water and natural weed hosts: First report on stinging nettle (Urtica dioica). Eur. J. Plant Pathol. 105:307-315.
35. Williamson, L., Hudelson, B. D., and Allen, C. 2002. Ralstonia solanacearum strains isolated from geranium belong to Race 3 and are pathogenic on potato. Plant Dis. 86:987-991.
